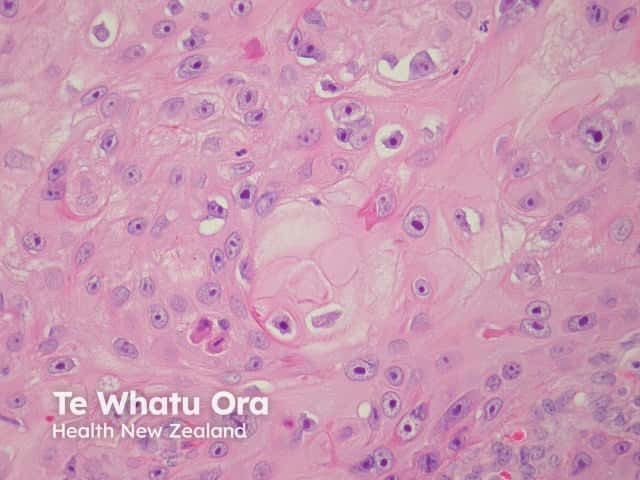
Pathology of squamous cell carcinoma keratinisation

Main menu
Common skin conditions
NEWS
Join DermNet PRO
Read more
Quick links
Diagnosis and testing Terminology
Author: Dr Anthony Yung, Dermatologist, Waikato District Health Board, Hamilton, New Zealand, 2007. Updated by A/Prof Amanda Oakley, Dermatologist, Hamilton, New Zealand; Dr Anthony Yung, 2016.
Introduction
How it works
Potential errors in diagnosis
Common inflammatory skin diseases
Dermatopathology is a subspecialty of pathology.
From a practical point of view, dermatopathology involves the microscopic examination, description and interpretation of biopsy specimens obtained from the skin. This is usually carried out by a general pathologist (who may or may not have had specific training in dermatopathology) or by a dermatopathologist (a doctor trained specifically in dermatopathology, but who may not have fully trained in anatomic pathology). Dermatopathologists often have training in clinical dermatology.
The interpretation of skin specimens can be complicated and difficult, as many diverse inflammatory skin diseases share the same basic inflammatory process or pattern. The final diagnosis requires clinical input and clinicopathological correlation.
Skin biopsy specimens are processed and then stained with Haematoxylin and Eosin (H&E). Eosin is acidic in nature and stains basic / alkaline / acidophilic structures red/pink. Haematoxylin is alkaline, and stains acidic / basophilic structures (eg, deoxynucleic acid, ribonucleic acid within cell nuclei) blue. Depending on the observed dermatopathological pattern present and/or the clinical features, special stains may be requested to identify agents causing the condition (e.g. bacteria or fungi), specific substances deposited in the skin (e.g. amyloid, iron or melanin) or specific markers to identify the origin, nature and distribution of cells in the specimen being examined.
The specimen is systematically examined by looking at the structure of the epidermis, dermis, subcutis, fascia and underlying structures. Based on the findings, the pathologist may come up with a definitive diagnosis, or list several possible explanations, creating a differential diagnosis. The integration of clinical information in conjunction with the pathological findings generates the final diagnosis, or list several possible explanations, creating a differential diagnosis. The integration of clinical information in conjunction with the pathological findings generates the final diagnosis.
Pathologists depend on the clinician supplying a good history and differential diagnosis, and their job is easier with a large biopsy sample than with a small one. Even then, the sample may not be representative of the disease as a whole.
Histological patterns of eczema, psoriasis, lichen planus, bullous pemphigoid, vasculitis and granuloma annulare are described below.
The histological features of eczema are:

Spongiotic eczema

Chronic lichenified eczema
Typical pathological features of chronic plaque psoriasis are:

Pathology of psoriasis x40

Pathology of psoriasis x200
The histological features of lichen planus are:

Pathology of lichen planus

Pathology of lichen planus
The histological features of bullous pemphigoid are:

Subepidermal bulla

Direct immune fluorescence
Note: vascular damage can be a secondary feature of conditions that are not primarily a vasculitis.
The histological features of leucocytoclastic (small vessel) vasculitis are:

Pathology of leucocytoclastic vasculitis

Pathology of leucocytoclastic vasculitis
The histological features of granuloma annulare are:

Pathology of granuloma annulare

path gannulare fig 3
The histological features of seborrhoeic keratosis may be quite varied and can overlap with solar lentigo, but typically show:
Irritated seborrhoeic keratoses may show many features suggestive of malignancy, and can be difficult at times to differentiate from squamous carcinoma.

Pigmented seborrhoeic keratosis

Seborrhoeic keratosis

Solar lentigo
The histological features of basal cell carcinoma are typically:

Pathology of basal cell carcinoma

Pathology of basal cell carcinoma
The histological features of actinic keratosis are:

Pathology of actinic keratosis

Pathology of actinic keratosis
The histological features of SCC in situ (intraepidermal carcinoma) show extensive overlap with actinic keratosis and are:

Pathology of squamous cell carcinoma in situ

Pathology of squamous cell carcinoma in situ
Histological features of invasive squamous cell carcinomas can vary, but in general are:

Pathology of invasive squamous cell carcinoma
Pathology of squamous cell carcinoma keratinisation
The histological features of epidermal inclusion cysts (epidermoid cysts) are:
Dermoid cysts differ by showing hair follicles and sebaceous glands in the wall and hair shafts in the contents
Trichilemmal (pilar) cysts show:

Epidermoid cyst

Trichilemmal cyst
The histological features of lentigines are:
The histological features of melanocytic naevi are:

Junctional naevus

Compound naevus

Intradermal naevus
The histological features of melanoma differ, depending on the type of tumour, but in general terms show:

Radial growth phase superficial spreading melanoma

Pathology of melanoma
The histological features of dermatofibroma are:

Pathology of dermatofibroma

Dermatofibroma pathology